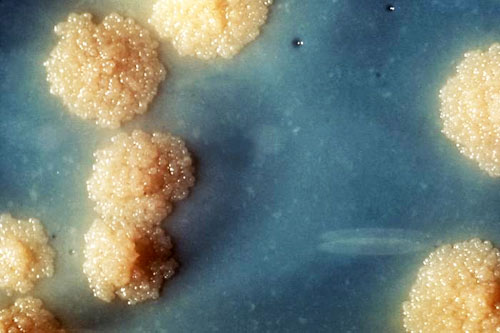

אספרגילוזיס ריאתית כרונית מסבכת שחפת ריאתית עם תמותה גבוהה לחמש שנים. החוקרים בחנו את ההימצאות של אספרגילוזיס ריאתית כרונית בקבוצת מטופלים זו.
במחקר השתתפו 398 מטופלים מאוגנדה. כלל המשתתפים עברו הערכה קלינית, צילומי חזה ומדידות IgG ספציפיות לאספרגילוס. 285 משתתפים עברו הערכה חוזרת לאחר שנתיים ובכלל זה CT חזה ב-73 מטופלים בהם היה חשד לאספרגילוזיס ריאתית כרונית. אספרגילוזיס ריאתית כרונית אובחנה במטופלים ללא שחפת פעילה אשר התגלו אצלם רמות מוגברות של IgG ספציפי לאספרגילוס, מאפיינים רדיולוגיים של אספרגילוזיס ריאתית כרונית ושיעול כרוני או המופטיזיס.
אספרגילוזיס ריאתית כרונית, כפי שהוגדרה על ידי החוקרים, התגלתה ב-14 (4.9%) מהמטופלים שעברו בדיקה חוזרת (רווח בר-סמך 95%: 2.8-7.9%). אספרגילוזיס ריאתית כרונית היתה נפוצה יותר בקרב אנשים עם קביטציה בצילום חזה (26% לעומת 0.8%, p<0.001) אך פחות נפוצה בקרב אנשים עם הדבקה בו-זמנית ב-HIVי(3% לעומת 6.7%; p=0.177).
השיעור השנתי של התפתחות CPA חדשה בין שני מפגשי המעקב היה 6.5% באנשים עם קביטציה בצילום חזה ו-0.2% באנשים ללא צילום (p<0.001). היעדר קביצה ועיבוי פלורלי בצילום חזה היה בעל ערך מנבא שלילי של 100% עבור אספרגילוזיס ריאתית כרונית. השילוב של IgG ספציפי לאספרגילוס מוגבר, שיעול כרוני או המופטיזיס וקביטציה בצילום חזה היה בעל רגישות של 85.7% וסגוליות של 99.6% לאבחנת אספרגילוזיס ריאתית כרונית.
החוקרים מסכמים כי אספרגילוזיס ריאתית כרונית הינה סיבוך נפוץ של שחפת ריאתית מטופלת עם קביטציה שארית בצילום חזה. צילום חזה לבד יכול לשלול אספרגילוזיס ריאתית כרונית. תוספת של בדיקת סרולוגיה יכולה לאבחן אספרגילוזיס ריאתית כרונית עם דיוק סביר.
מקור:
Page, I.D. et al. (2019) European Respiratory Journal. DOI: 10.1183/13993003.01184-2018